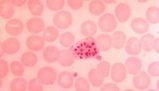

Concetti Chiave
- L'apparato circolatorio distribuisce sangue per nutrire, depurare e difendere l'organismo, trasportando nutrienti e raccogliendo rifiuti.
- Composto da sangue, vasi sanguigni e cuore, il sistema circolatorio umano presenta una circolazione chiusa, doppia e completa.
- Il cuore, situato tra i polmoni e il diaframma, è suddiviso in quattro camere e dotato di valvole che garantiscono il flusso unidirezionale del sangue.
- Il ciclo cardiaco include diastole e sistole, permettendo al cuore di pompare sangue costantemente, alimentato dalle arterie coronarie.
- Il sistema circolatorio si divide in piccola e grande circolazione, assicurando lo scambio di gas nei polmoni e la distribuzione di ossigeno nel corpo.
Funzioni dell'apparato circolatorio
L’Apparato Circolatorio ha il compito di distribuire il sangue in tutto l’organismo svolgendo diverse funzioni:
- una funzione nutritiva perchè trasporta le sostanze nutritive a tutto l’organismo;
- -una funzione depurativa in quanto raccoglie gli elementi di rifiuto, destinati a essere eliminati attraverso i reni;
- Una funzione difensiva per le proprietà di alcune cellule che hanno il compito di difendere l’organismo da batteri e virus.
Componenti dell'apparato circolatorio
L’Apparato Circolatorio è formato da:
- Un tessuto liquido, il sangue;
- Una rete di canali in cui esso scorre, i vasi sanguigni (vene e arterie);
- Un muscolo, il cuore.
Nell’uomo, come in tutti i mammiferi, la circolazione è:
- Chiusa, cioè il sangue non esce mai dai vasi sanguigni, che lo tengono separato dal liquido interstiziale ( liquido acquoso presente fra le cellule di un tessuto);
- Doppia, cioè il sangue circola dal cuore ai polmoni, per gli scambi gassosi ( prendere e rilasciare l’ossigeno e l’anidride carbonica), e dal cuore al resto del corpo per svolgere le proprie funzioni;
- Completa: il sangue ossigenato non si mescola mai col sangue con anidride carbonica
Composizione del sangue
Il sangue è formato da:
- Dal plasma ( la parte liquida)
- Da elementi cellulari:
- Globuli rossi,
- Globuli bianchi,
- Piastrine.
Il cuore è situato nel torace, tra i due polmoni e il diaframma.
Lo avvolgono tre diverse membrane chiamate:
- endocardio, il tessuto più interno;
- miocardio, il tessuto intermedio;
- pericardio, il tessuto più esterno.
Il cuore è un muscolo dalla grandezza di un pugno.
E’ cavo all’interno ed è suddiviso in quattro camere: due atri ( destro e sinistro) e due ventricoli ( destro e sinistro).
Atri e ventricoli dello stesso lato comunicano tra di loro attraverso una valvola: la volta tricuspide a destra e la bicuspide a sinistra.
Il cuore destro e il cuore sinistro sono nettamente separati dal setto atrio-ventricolare, che assicura la distinzione fra sangue venoso e sangue arterioso. La parte destra è denominata cuore venoso in quanto raccoglie il sangue che proviene dalla periferia e che torna carico di anidride carbonica, mentre la parte sinistra è detta cuore arterioso in quanto il sangue è quello carico di ossigeno che proviene dai polmoni per essere reimmesso nel circolo.
Valvole cardiache
Valvole cardiache
Le quattro valvole poste a livello delle aperture atrio-ventricolari, sono rispettivamente:
- la tricuspide, che separa l’atrio destro dal ventricolo destro;
- la polmonare, posta tra il ventricolo destro e l’arteria polmonare;
- a sinistra la bicuspide è interposta tra l’atrio e il ventricolo, mentre la valvola aortica regola il passaggio del sangue tra il ventricolo sinistro e l’aorta.
Queste valvole, in condizioni funzionali normali, consentono il flusso del sangue in una sola direzione ( si definiscono infatti valvole unidirezionali) dall’atrio al ventricolo, dal ventricolo all’arteria.
Ciclo cardiaco
Il cuore è una pompa che serve per mettere la circolazione sanguigna. Il ciclo cardiaco si svolge in tre tempi:
- la diastole, comporta il rilasciamento degli atri, svuotate in precedenza, che accolgono il sangue proveniente dalle vene polmonari a sinistra e dalle vene cave a destra;
- la sistole atriale, comporta la contrazione degli atri, e ne provoca lo svuotamento totale;
- la sistole ventricolare, comporta la contrazione dei ventricoli. In questo modo, il sangue si riversa nelle arterie e i ventricoli si svuotano.
Circolazione coronarica
Il cuore pompa il sangue in tutti i tessuti dell’organismo e questo lavoro lo compie incessantemente, contraendosi e rilassandosi ritmicamente. Per vivere e per svolgere la sua funzione di pompa il muscolo cardiaco (miocardio) ha bisogno del continuo, ininterrotto apporto di sangue che riceve attraverso le arterie coronarie. Sono due arterie, l’arteria coronaria destra e l’arteria coronaria sinistra, che prendono origine dall’aorta, appena sopra la valvola aortica. Disposte superficialmente, nel solco esistente fra gli arti e i ventricoli, circondano il cuore in senso trasversale formando come una corona attorno ad esso. Da ciò appunto deriva il nome: coronarie. La circolazione coronarica è completata dalle vene coronarie che scaricano il loro sangue nel senso coronarico, che a sua volta lo scarica nell’atrio destro.
Circuiti del sistema circolatorio
Il nostro sistema circolatorio è formato da due circuiti separati. La piccola circolazione parte dal ventricolo destro e porta il sangue dal cuore ai polmoni dove i globuli rossi cedono anidride carbonica e si caricano di ossigeno per poi tornare verso il cuore.
La grande circolazione parte invece dal ventricolo sinistro e distribuisce sangue carico di ossigeno in tutto il corpo. Passando dai capillari il sangue cede ossigeno alle cellule e torna verso il cuore rientrando nell’atrio destro e ricomincia da capo. In realtà quando ascoltiamo il battito del cuore, ciò che sentiamo non è la contrazione del muscolo, ma sono le grandi valvole bicuspide e tricuspide che sbattono chiudendosi.
Tipi di vasi sanguigni
I vasi, all’interno dei quali circola il sangue, sono:
- le arterie, che conducono il sangue dal cuore alla periferia;
- le vene, che conducono il sangue dalla periferia al cuore;
- e i vasi capillari, nei distretti in cui avvengono gli scambi con i tessuti.
Sangue arterioso= Sangue
Sangue venoso= Sangue deossigenato
Le arterie più prossime al cuore sono elastiche: la spinta alla circolazione del sangue è offerta dalla contrazione del cuore e questi vasi devono essere in grado di dilatarsi opportunamente. Via via che ci si allontana dal cuore la propulsione è assicurata dalla contrazione muscolare dei vasi. I vasi della circolazione reflua ( cioè di ritorno al cuore), le vene, sono dotati di una parete muscolare esigua, ma presentano numerose valvole a nido di rondine che impediscono il riflusso del sangue. Molto importante per il ritorno del sangue al cuore è l’attività fisica, infatti la contrazione muscolare determina una pressione sulle vene che impedisce il ristagno di liquidi soprattutto a livello degli arti.
Domande da interrogazione
- Quali sono le principali funzioni dell'Apparato Circolatorio?
- Quali sono i componenti principali dell'Apparato Circolatorio?
- Come si caratterizza la circolazione sanguigna nei mammiferi?
- Qual è la funzione delle valvole cardiache?
- In cosa consiste la piccola e grande circolazione?
L'Apparato Circolatorio ha funzioni nutritive, depurative e difensive, trasportando sostanze nutritive, eliminando rifiuti e difendendo l'organismo da batteri e virus.
L'Apparato Circolatorio è composto dal sangue, dai vasi sanguigni (vene e arterie) e dal cuore.
Nei mammiferi, la circolazione è chiusa, doppia e completa, con il sangue che non esce dai vasi, circola tra cuore e polmoni e non mescola sangue ossigenato con quello ricco di anidride carbonica.
Le valvole cardiache, come la tricuspide e la bicuspide, permettono il flusso unidirezionale del sangue tra atri e ventricoli e tra ventricoli e arterie.
La piccola circolazione porta il sangue dal cuore ai polmoni per lo scambio gassoso, mentre la grande circolazione distribuisce sangue ossigenato in tutto il corpo.

Accedi a tutti gli appunti
Accedi a tutti gli appunti
 Tutor AI: studia meglio e in meno tempo
Tutor AI: studia meglio e in meno tempo